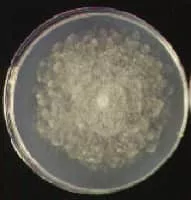

Phytophthora Nicotianae
| Use attributes for filter ! | |
| Scientific name | Phytophthora nicotianae |
|---|---|
| Rank | Species |
| Higher classification | Phytophthora |
| Family | Peronosporaceae |
| Order | Peronosporales |
| Phylum | Heterokontophyta |
| Date of Reg. | |
| Date of Upd. | |
| ID | 986195 |
About Phytophthora Nicotianae
Phytophthora nicotianae or Black Shank is an oomycete belonging to the order Peronosprales and family Peronosporaceae.